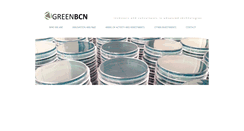
Desktop Preview
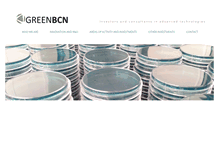
Tablet Preview

GREENBCN.COM
GREENBCNInvestors and consultants in advanced technologies. AREAS OF ACTIVITY AND INVESTMENTS.
http://www.greenbcn.com/

Investors and consultants in advanced technologies. AREAS OF ACTIVITY AND INVESTMENTS.
http://www.greenbcn.com/
TODAY'S RATING
>1,000,000
Date Range
HIGHEST TRAFFIC ON
Sunday

LOAD TIME
0.6 seconds
16x16
32x32

64x64

128x128

160x160

192x192

256x256
NAVAL, JORDI
GUAR●●●●IA 3
BAR●●●ONA , BARCELONA, 08017
ES
View this contact
GREEN BCN CONSULTING SERVICES SL
GUAR●●●●IA 3
BAR●●●ONA , BARCELONA, 08017
ES
View this contact
GREEN BCN CONSULTING SERVICES SL
GUAR●●●●IA 3
BAR●●●ONA , BARCELONA, 08017
ES
View this contact
16
YEARS
4
MONTHS
20
DAYS

ARSYS INTERNET, S.L. D/B/A NICLINE.COM
WHOIS : whois.nicline.com
REFERRED : http://www.nicline.com
PAGES IN
THIS WEBSITE
4
SSL
EXTERNAL LINKS
0
SITE IP
217.76.142.124
LOAD TIME
0.59 sec
SCORE
6.2
GREENBCN | greenbcn.com Reviews
https://greenbcn.com
Investors and consultants in advanced technologies. AREAS OF ACTIVITY AND INVESTMENTS.
 greenbcn.com
greenbcn.com
GREENBCN
http://www.greenbcn.com/innovation.html
Investors and consultants in advanced technologies. AREAS OF ACTIVITY AND INVESTMENTS. Green BCN offers unique consulting and innovative services in R&D, in a number of cutting edge technologies, including health and technology. We provide research, development and innovation services in the following areas:. Drug discovery and clinical development. New IT technologies for health care. Systems biology and advanced biocomputing strategies.
GREENBCN
http://www.greenbcn.com/whoweare.html
Investors and consultants in advanced technologies. AREAS OF ACTIVITY AND INVESTMENTS. We are a group of seasoned and experienced professional and investors in several areas of knowledge. Green BCN managers accumulate more than 20 years of experience in the following areas:. Drug discovery and clinical development. New IT technologies for health care. Systems biology and advanced biocomputing strategies. New omics sciences and applications to drug discovery, nutraceutics and cosmetics areas.
GREENBCN
http://www.greenbcn.com/investments.html
Investors and consultants in advanced technologies. AREAS OF ACTIVITY AND INVESTMENTS. GREEN BCN owns also a fantastic country house in Mas Montagut, located in the small village of Fontanals de Cerdanya. See the map here. The house is available for rent, by the season or by weeks. Please contact us for more information.
GREENBCN
http://www.greenbcn.com/areas.html
Investors and consultants in advanced technologies. AREAS OF ACTIVITY AND INVESTMENTS. We work in R&D within the Biopharma industry, Information Technologies and new mobile and internet applications. Green holds relevant IP in several industries, and develops and valuates new prototypes and technologies. Green hosts unique IP such as: NEW COMBINATION THERAPIES FOR TREATING NEUROLOGICAL DISORDERS, filed as provisional patent in the USPTO with the application number 61/552922, on 28/10/2011.
TOTAL PAGES IN THIS WEBSITE
4
Green Building Construction and Electric
Green Building Construction and Electric. Green Building Construction & Electric. 10-YEAR RECORD OF SUCCESS OVERSEEING ALL PHASES OF CONSTRUCTION, INFRASTRUCTURE, ELECTRICAL AND BUILDING PROJECTS FOR GOVERNMENT AND PRIVATE CLIENTS. 10-year record of success! Green Building Construction & Electric. 10-YEAR RECORD OF SUCCESS OVERSEEING ALL PHASES OF CONSTRUCTION, INFRASTRUCTURE, ELECTRICAL AND BUILDING PROJECTS FOR GOVERNMENT AND PRIVATE CLIENTS.
Green Building Construction & Electric
National Association of Minority. AGC Shreveport Bossier Chapter. Small Business Administration (SBA).
Beachy Cove ElementaryEnvironmental Agency - Home
Links for a Greener YOU! Please support our CANS FOR KIDS. Project during the month of May! PRINT RECYCLING PRIZE TICKETS! We were very proud to celebrate the grand opening of our outdoor classroom in 2013. Our students are strongly encouraged to bring lunch orders in reusable bags to avoid the disposal of plastic baggies. We have a school-wide paper recycling program. We collect beverage container recyclables in our parking lot every Tuesday morning. We take part in many projects and events.
greenbcert GmbH | Ihr Generalist für Gebäudezertifizierung
Ökologischer. Nachhaltiger. Wirtschaftlicher. Greenbcert - Ihr Generalist für Gebäudezertifizierung. Greenbcert unterstützt Sie auf Ihrem Weg zum nachhaltigen und ausgezeichneten Gebäude. Wir übernehmen alle mit der Zertifizierung einhergehenden Aufgaben und Nebenleistungen. DGNB, BNB, LEED. Wir sind greenbcert: Ihr Generalist für Gebäudezertifizierungen. DGNB, BNB, LEED. Wir übernehmen gemeinsam mit Ihnen die Verantwortung für nachkommende Generationen. Tel: 49.(0)30.346 550 1-00.
greenbcert GmbH | Ihr Generalist für Gebäudezertifizierung
Ökologischer. Nachhaltiger. Wirtschaftlicher. Greenbcert - Ihr Generalist für Gebäudezertifizierung. Greenbcert unterstützt Sie auf Ihrem Weg zum nachhaltigen und ausgezeichneten Gebäude. Wir übernehmen alle mit der Zertifizierung einhergehenden Aufgaben und Nebenleistungen. DGNB, BNB, LEED. Wir sind greenbcert: Ihr Generalist für Gebäudezertifizierungen. DGNB, BNB, LEED. Wir übernehmen gemeinsam mit Ihnen die Verantwortung für nachkommende Generationen. Tel: 49.(0)30.346 550 1-00.
GREENBCN
Investors and consultants in advanced technologies. AREAS OF ACTIVITY AND INVESTMENTS.
Korean Cosmetics Custom Design OEM Products | Greenb Cosmetics
Tube Lip Gloss" /. Volume and Long Lash Mascara. Vivid Color Liquid Eyeliner. UV Protect Lip Gloss. We’re a manufacturer and exporter in. Korean cosmetics as leading the beauty industry for years. We’re extremely experienced and professional in color Korean cosmetics such as mascara, eyeliner, lip gloss, lipstick, powder, nail polish, perfume etc. Volume and Long Lash Mascara. Vivid Color Liquid Eyeliner. Volume and Curling Mascara. Well-Defined Look Liquid Eyeliner. UV Protect Lip Gloss.
www.greenbcrealty.com [10]
Grennbd-IT | IT for changing & prosperity
880) 1726 19 29 59. 880) 1918 69 49 99. Logo & Graphics Design. Logo & Graphics Design. Logo & Graphics Design. We develop dynamic, cost effective and easy to use websites for companies around the globe. We love to help small businesses establish or improve their image and web presence, but whether your company is large or small, we have the time, expertise, and creativity to be an integral part of your web marketing solution. Having hands on experience in creating innovative. Logo and Graphics Design.
Green Bangladesh
Thursday, March 29, 2018. ব শ ব র সবচ য খ র প 'স প র গন র য য ' আক র ন ত ব যক ত চ হ ন ত. বল ট য ম প র : অস ট র ল য ত ক মন প রত ক র য? ব শ বক প প রভ ব পড ব? FirstBuild Opal Flake Ice Maker Release Date, Price and Specs – CNET. প রথমব র র মত প ক স ত ন ফ রল ন ম ল ল. আয রল য ন ড র প রথম নগ ন স কত আসল ক মন. চ ন-ম র ক ন ব ণ জ য য দ ধ ত ব র প রভ ব ফ লব ব শ ব অর থন ত ত ’. ফ সব ক গ গল ও ট ইট র র প রধ ন র ব র দ ধ সমন. স থ ন য় সরক র র ১৩৩ জ য়গ য় ভ ট ব হস পত ব র. ভ রত প র ষ র চ য ম য দ র ক য ন স র র হ র ব শ ক ন?
Green B Designs